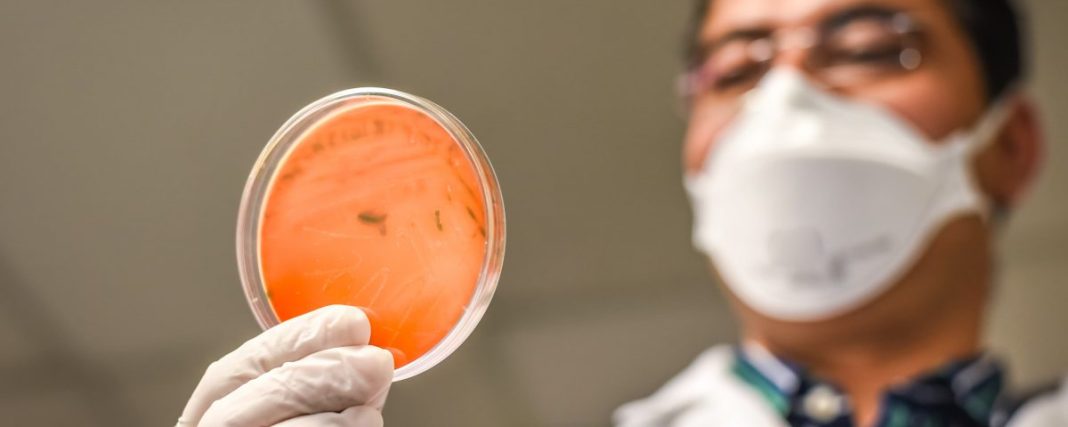

En el marco de las fiscalizaciones que realiza la Oficina Provincial de la Seremi de Salud de Los Lagos en Osorno, es que se realizaron diversos análisis en fábricas de alimentos de quesos y cecinas.
Las pesquisas arrojaron que tres fábricas de cecinas, dos ubicadas en Purranque y una de Osorno; además de otra planta de quesos, también en Purranque, contenían productos con listeria, indicó Claudio Millaguín, jefe provincial del servicio.
Debido a esta situación, la autoridad sanitaria determinó la prohibición de funcionamiento de todas las fábricas antes mencionadas, las cuales se deberán someter a un sumario para determinar el origen de este foco bacteriano en productos que incluso se comercializaron, precisó Millaguín.
La listeria, según especialistas, es una enfermedad provocada por una bacteria, la cual puede tener graves, e incluso, fatales consecuencias en quienes consuman alimentos infectados, sobre todo, en embarazadas, recién nacidos, adultos mayores, enfermos crónicos e inmunodeprimidos.